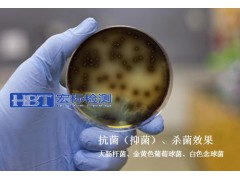

远红外检测,国内外专业第三方检测机构,检测周期短,费用低,出具[专业]检测报告远红外检测,主营业务 :可靠性检测,材料特性检测,远红外检测,有害物质检测,成分分析等。
宏标检测一个专业全面的、经验丰富的认证服务机构,已有超过十年的检测认证经验,拥有技术团队为您提供检测认证需求,服务电话:159-1542-8783
尤其在具有辐射功能的各种能量光电子产品的红外辐射特性检验方面具有国际先进、国内领先的能力与优势。产品检验范围覆盖了红外能量光电子产品,包括:红外光波浴房、红外理疗仪、红外仪、和其他远红外功能纺织品、多功能用品材料等。
专业领域的具有第三方公正性的实验室,竭诚为您的企业、产品先进的科技支撑。
主要检测项(远红外功能、抗菌杀菌、负离子、磁性检测)
1、 远红外法向发射率
2、 红外辐射波长范围
3、 法向发射率提高值
4、 红外透过率
5、 红外反射率
6、 光谱发射率
7、 灰分
8、 红外辐射升温速率
9、 磁感应强度
10、 红外线作用效果热图(模特使用效果)
11、 抗菌性能检测
12、 生物微循环检测
13、 负离子浓度检测
出具国家认可权威报告,具有企业信息AS和CMA双资质报告,检测结果获得了国际实验室认可合作组织(ILAC)的国际互认。
宏标检测提供材料、纺织品及电子电器产品方面的检测,包括负离子、远红外、磁功能测试鉴定及相关理化性能检测,更多详情可以咨询:159-1542-8783!